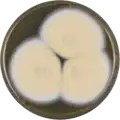
Aspergillus nakazawae growing on MEAOX plate

Aspergillus nakazawae
| Aspergillus nakazawae | |
|---|---|
| Scientific classification | |
| Kingdom: | Fungi |
| Division: | Ascomycota |
| Class: | Eurotiomycetes |
| Order: | Eurotiales |
| Family: | Aspergillaceae |
| Genus: | Aspergillus |
| Species: | A. nakazawae
|
| Binomial name | |
| Aspergillus nakazawae Sakaguchi, Iizuka & M. Yamazaki (1950)[1]
| |
Aspergillus nakazawae is a species of fungus in the genus Aspergillus. The species was first described in 1950.[1]
Growth and morphology
A. nakazawae has been cultivated on both Czapek yeast extract agar (CYA) plates and Malt Extract Agar Oxoid® (MEAOX) plates. The growth morphology of the colonies can be seen in the pictures below.
-
 Aspergillus nakazawae growing on CYA plate
Aspergillus nakazawae growing on CYA plate -
Aspergillus nakazawae growing on MEAOX plate
Aspergillus nakazawae growing on MEAOX plate
References